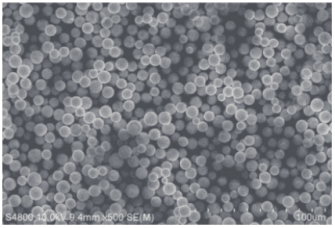

Bio-C8( 2 )( 8μm,100 Å )填料
- 111208101
- 苏州赛分
- 江苏省苏州市
- 现货
- 按需定制
- 议价
- 2022-12-17 16:30:04
苏州赛分科技股份有限公司
一键申请试用
咨询
加入意向单
联系方式

技术参数
| 型号 | Bio-C8(2) | 测试方法 |
|---|---|---|
| 粒径大小 | 8.0μm | Coulter Multisizer |
| 粒径分布 | ≤1.35 | Coulter Multisizer |
| 孔径 | 100 Å | B.E.T法 |
| 密度 | 0.65 g/mL | 一 |
| 比表面积 | 310 m2/g | B.E.T法 |
| 孔容 | 1.0 mL/g | B.E.T法 |
| 碳载量 | 12% | CHN分析仪 |
| 金属(Fe)含量 | <10 ppm | ICP |
| 金属(Al)含量 | <10 ppm | |
| 金属(Na)含量 | <10 ppm |
批次稳定性
| 项目 | 规格 | 项目 | |||
|---|---|---|---|---|---|
| Lot1 | Lot2 | Lot3 | Lot4 | ||
| 平均粒径 (μm) D50 | 7.5-8.5 | 7.9 | 8.1 | 8.3 | 7.9 |
| 粒径分布D40/D90 | ≤1.35 | 1.3 | 1.3 | 1.25 | 1.26 |
| 孔径 (Å) | 95-135 | 12.8 | 12.9 | 12.5 | 12.8 |
| 比表面积 (m2/g) | 285-345 | 310 | 309 | 309 | 309 |
| 孔容 (mL/g) | 0.85-1.10 | 0.98 | 1.00 | 0.95 | 0.99 |
| 碳载量 (%) | 10.3-13.5 | 11.7 | 11.9 | 11.8 | 11.7 |
| 金属 (Fe)含量 (ppm) | <10 | 0.5 | 0.5 | 0.5 | 0.4 |
| 金属 (AI)含量 (ppm) | <10 | 0.4 | 0.4 | 0.3 | 0.5 |
| 金属 (Na)含量 (ppm) | <10 | 0.6 | 0.5 | 0.5 | 0.5 |
参数对比
1.比表面积测试方法:
B.E.T法:Outgassing conditions:80 min 80 °C ; Adsorbate : N2; Sample Mass : 0.1268 grams ; HK model :N2_C.HKM
2.电镜图
3.耐碱性测试
在位清洗 (CIP)条件:450个柱体积的碱性流动相在位清洗并进行色谱柱性能测试。
色谱柱:4.6x250 mm
流动相:MeOH/0.1 M NaOH aq. ( pH=13) =70/30
流速:2.0 mL/min
柱温:25°C
每50cv清洗后进行QC测试:
样品:1.Naphthalene , 2.Insulin




● 通过 450 CV 的碱性溶液在位清洗,发现萘以及胰岛素相对于其初始保留时间的比值为 92%,这说明Bio-C8 ( 2 ) 填料只发生了轻微的退化 ( Bio-C8 ( 2 ) 与供应商 K 填料性能类似 )。
● Bio-C8 ( 2 ) 填料能够支持 0.1 M 碱在位清洗,对于特定样品的碱清洗的浓度以及循环次数需要通过实验进行验证。
| 产品名称 | 粒径(μm) | 孔径(Å) | 订货号 |
|---|---|---|---|
| Bio-C8(2)(8 μm,100 Å) | 8 | 100 | 111208101 |